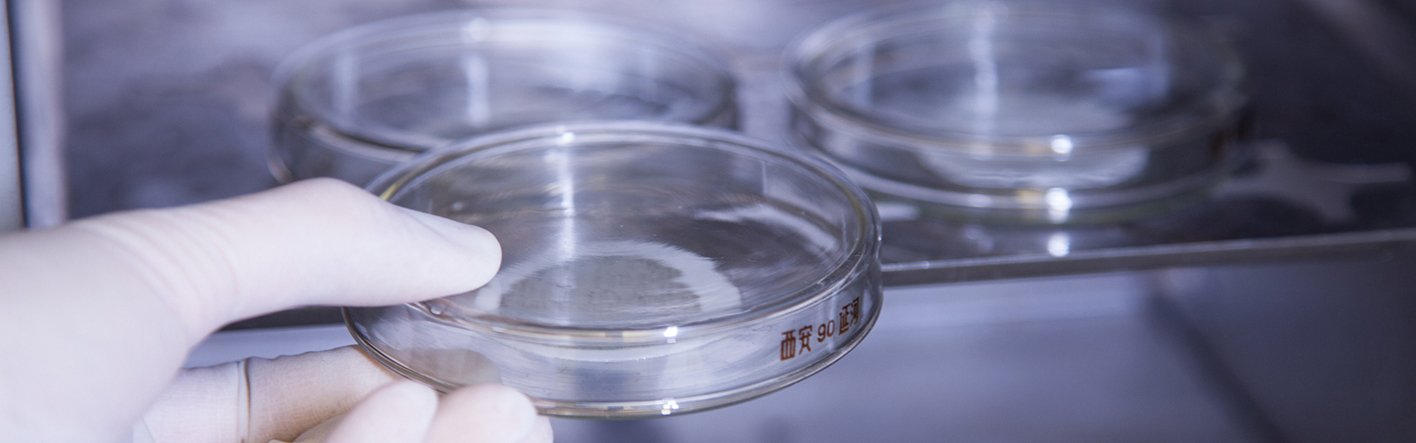

石棉鑒定
- 實地抽取塊狀樣本
- 利用偏光顯微鏡之色散染色技術進行分析
- 利用重量測定及點子計算法以判定含石棉物品
石棉監測
- 實地抽取空氣微塵樣本以監測飄散在空氣中的石棉纖維
- 利用相襯顯微鏡對濾膜上的纖維進行點算以評估空氣中的纖維濃度
工程實例
石棉鑒定
日期: 2025年5月
支部: 石棉鑒定及監測
項目: 尖沙咀馬可波羅香港酒店外牆煙囪
客戶: 安達環境(香港)有限公司
石棉鑒定
日期: 2024年3月至現在
支部: 石棉鑒定及監測
項目: 政府處所含石棉材料的盤點調查(B組 - 第8批)
客戶: 艾奕康有限公司
石棉監測
日期: 2024年12月至現在
支部: 石棉鑒定及監測
項目: 維修及建築物料測試定期合約 2024-2027 (合約 B1) - 石棉測試及監測
客戶: 香港房屋委員會
石棉監測
日期: 2025年1月至5月
支部: 石棉鑒定及監測
項目: 青山發電廠石棉水泥管道
客戶: 屋宇環境科技有限公司